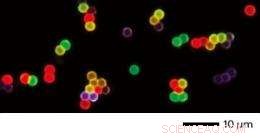
Innovative Nanoparticle Design Converts Low‑Energy Light into High‑Energy Emission for Advanced Biological Imaging

Upconverted emission from core-shell nanoparticles can take on different colors, by doping the shells with different activator elements. Copyright : 2011 NPG
The light that a luminescent particle emits is usually less energetic than the light that it absorbs. Some applications require the emitted light to be more energetic, but this so-called upconversion process has been observed in only a small handful of materials. Xiaogang Liu at the A*STAR Institute of Materials Research and Engineering and co-workers have now succeeded in expanding the list of upconversion materials, easing the path to new applications.
Traditional upconversion particles are distinguished by their evenly-spaced or ‘ladder-like’ energy levels which their internal electrons can take on. The even spacings allow an electron to be promoted up in energy many times consecutively, by absorbing many photons of the same color. When an electron that has been promoted to a high energy finally relaxes back to the lowest-energy state, it emits a photon which is more energetic than the photons that excited it to begin with.
Nanoparticles doped with elements from the lanthanide group of the periodic table are capable of upconversion, and are useful for biological imaging because their high-energy emission can be clearly distinguished from background noise. However, only three elements from the lanthanide series are efficient at upconversion: erbium, thulium, and holmium. This list is so short because of the simultaneous requirements that an upconversion particle exhibit a ladder-like electronic energy structure, and also efficient emission.
Liu and colleagues solved this problem by using different lanthanides to perform different stages of the upconversion process. Sensitizer elements absorb incident light, and transfer the absorbed energy to nearby accumulators, whose electrons rise to high energy levels. Then, the energy stored in accumulators transfers by hopping through many migrators, until an activator is reached. Finally, the activator releases a high-energy photon.
By assigning different elements to each of these four functions, the researchers were able to ease the requirements on any individual element. In addition, unwanted interactions among different elements were avoided by separating them spatially inside a single spherical nanoparticle that has sensitizers and accumulators in the core, activators in the shell and migrators in both the core and the shell.
This design allowed Liu and his team to observe a spectrum of colors from the upconverted emission of europium, terbium, dysprosium and samarium (see image). The same approach may also allow other elements to emit efficiently. “Our results may lead to advances in ultrasensitive biodetection,” says Liu, “and should inspire more researchers to work in this field.”